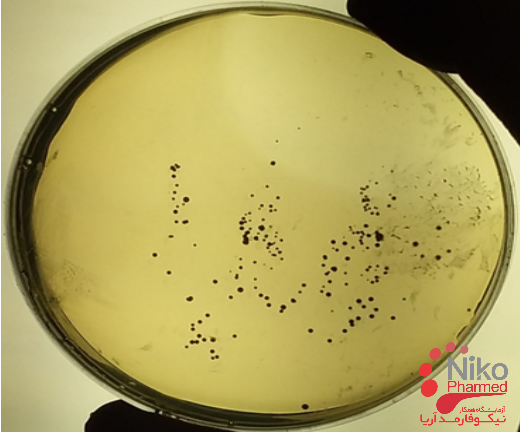
اهمیت انجام آزمونهای میکروبی شیر

شیر و فرآورده های شیری، فراوردههای غذایی مفیدی هستند که هم از نظر ارزش تغذیهای و هم از نظر صنعتی اهمیت ویژهای دارند. با این حال، شیر به شدت مستعد فساد توسط میکروارگانیسمها است و ارزیابی میکروبی این فراورده نقش عمدهای در صنایع لبنی در کنترل کیفیت شیر ایفا میکند. اندازهگیری بار میکروبی شیر یکی از آزمونهایی است که در مجموعه آزمایشگاههای همکار نیکوفارمد آریا انجام میشود.
شیر گاو از انواع مواد مغذی مانند چربیها، پروتئینها، مواد معدنی، ویتامینها، کربوهیدراتها و آب تشکیل شده است و بنابراین به عنوان یک محیط عالی برای رشد باکتریها محسوب میشود. بنابراین آلودگی این محصول با تعداد کم میکروارگانیسمها میتواند منجر به تکثیر آنها و ایجاد فساد یا مسمومیت در آن شود. اندازهگیری بار میکروبی شیر یکی از آزمونهایی است که در مجموعه آزمایشگاههای همکار نیکوفارمد آریا انجام میشود.
اهمیت انجام آزمونهای میکروبی شیر
شیر با توجه به شرایط آن، میتواند به عنوان ناقل برخی بیماریهای غذازاد عمل کند و همچنین میتواند باعث انتقال میکروارگانیسمهای بیماریزا از گاو به انسان شود. باکتریها از منابع مختلفی مانند کارکنان کارگاههای تولید لبنیات، از طریق بدن گاو آلوده، از طریق گرد و غبار در انبارها یا ظروف یا سایر تجهیزات میتوانند وارد شیر شوند. اندازهگیری بار میکروبی شیر یکی از آزمونهایی است که در مجموعه آزمایشگاههای همکار نیکوفارمد آریا انجام میشود.
انواع میکرواورگانیسم های موجود در شیر
برخی از باکتری مانند مایکوباکتریوم، بروسلا، استرپتوکوکوس و کوکسیلا میتوانند از طریق گاوهای بیمار وارد شیر شده و منجر به بروز بیماری در فرد مصرف کننده شوند. برخی از باکتریها مانند سالمونلا، شیگلا، کورینه باکتریوم و استرپتوکوکوس نیز میتوانند از طریق افراد آلوده وارد شیر شوند. میکروارگانیسمهای سرمادوست مهمترین گروه میکروبهای موجود در شیر و محصولات لبنی هستند. به عنوان مثال باکتری سودوموناس به عنوان مهمترین میکروارگانیسمهای سرمادوست در نظر گرفته میشود که از طریق تولید آنزیمهای لیپولیتیک و پروتئولیتیک در فساد شیر نقش مهمی دارد. اندازهگیری بار میکروبی شیر یکی از آزمونهایی است که در مجموعه آزمایشگاههای همکار نیکوفارمد آریا انجام میشود.
بررسی تعداد این میکروارگانیسمها با روشهای میکروبیولوژی در شیر به عنوان به عنوان اندازهگیری بار میکروبی شناخته میشود. اندازهگیری بار میکروبی شیر نقش مهمی در جلوگیری از شیوع بیماریهای غذازاد دارد. در صورت عدم بررسی این عوامل، مسمومیتهای غذایی مختلفی بروز میکند که به عنوان عامل گاستروانتریت باکتریایی در انسان در نظر گرفته میشود. اندازهگیری بار میکروبی شیر یکی از آزمونهایی است که در مجموعه آزمایشگاههای همکار نیکوفارمد آریا انجام میشود.
وجود کلیفرمها در شیر نشان دهنده انتقال آلودگی مدفوعی به فراورده مذکور است. لازم به ذکر است که پس از اتمام فرآیند پاستوریزه کردن، شیر میتواند از طریق دستکاریهای غیربهداشتی آلوده به میکروارگانیسمهای مدفوعی شود. باکتریهای کلیفرم شامل اشریشیا کلی و انتروباکتر آئروژنز میکروارگانیسمهای ساکن طبیعی روده بزرگ انسان هستند. یک میکروارگانیسم مهم منتقله از طریق غذا اشریشیا کلی نوع انتروپاتوژن است که میتواند باعث ایجاد اسهال و حتی عوارض منجر به مرگ در فرد مصرف کننده شود. اندازهگیری بار میکروبی شیر یکی از آزمونهایی است که در مجموعه آزمایشگاههای همکار نیکوفارمد آریا انجام میشود.
در سال 1985 تقریباً 18000 نفر در ایلینوی شمالی و ایالت های اطراف آن بیماری شدید دستگاه گوارش را به دلیل مصرف شیرهای آلوده به سالمونلا تیفی موریوم تجربه کردند. این آلودگی در شیر تهیه شده توسط یک کارخانه لبنیات که توسط یک فروشگاه زنجیرهای بزرگ مواد غذایی اداره میشد، مشاهده شد. در نهایت مشخص شد که بروز این عوارض گوارشی به دلیل پاستوریزاسیون نامناسب بوده است که موجب بقای باکتری سالمونلا در شیر شده است. اندازهگیری بار میکروبی شیر یکی از آزمونهایی است که در مجموعه آزمایشگاههای همکار نیکوفارمد آریا انجام میشود.

افزایش بار میکروبی شیر بیش از حد مجاز ارائه شده اغلب در اثر عدم رعایت موثر نکات بهداشتی ایجاد میشوند. بار میکروبی شامل باکتریهایی هستند که نشان دهنده مسیر آلودگی محصول هستند. از این دسته میتوان به باکتریهای مزوفیل هوازی، باکتریهای سرماگرا و کلیفرمها اشاره کرد. میکروارگانیسمهای مزوفیل هوازی شامل باکتریهایی هستند که در دمای 25 الی 40 درجه سلسیوس رشد بهتری دارند. این میکروارگانیسمها که گاهی تحت عنوان شمارش کلی میکروبی نیز بررسی میشوند. شمارش کلی میکروبی شامل طیف بزرگی از باکتریها هستند که عموما از طریق بدن حیوان شیرده و محیط وارد شیر شده و در صورت عدم نگهداری فراورده در دمای مناسب، به سرعت تا حد بسیار زیادی تکثیر مییابند. آزمون اندازهگیری بار میکروبی شیر یکی از آزمونهایی است که در مجموعه آزمایشگاههای همکار نیکوفارمد انجام میشود.
وجود یا عدم وجود بار میکروبی ملاکی برای ارزیابی شیر و فراوردههای لبنی نیست. چون در حالت طبیعی شیر یک فراورده استریل نبوده و حاوی مقداری میکروارگانیسم مزوفیل هوازی است. اما افزایش این تعداد میتواند نشان دهنده عدم رعایت یکی از اصول بهداشتی در فراوری محصول باشد. طبق استانداردهای متعددی اگر میزان بار میکروبی شیر بیشتر از 105 عدد در هر میلیلیتر باشد، کیفیت محصول ضعیف ارزیابی میگردد. در مقابل چنان چه تعداد این میکروارگانیسمها در نمونه کمتر از 103 باکتری در هر میلیلیتر باشد، کیفیت آن خوب در نظر گرفته میشود. آزمون اندازهگیری بار میکروبی شیر یکی از آزمونهایی است که در مجموعه آزمایشگاههای همکار نیکوفارمد انجام میشود.
کارشناسان پاستوریزاسیون را فرآیندی برای گرم کردن مایعات به ویژه شیر، تا دمای بین 55 تا 70 درجه سانتیگراد تعریف میکند تا باکتریهای مضر را بدون تغییر در ترکیب، طعم یا ارزش غذایی فراورده از بین ببرد. بنابراین پاستوریزاسیون شیر به عنوان یک اقدام بهداشت عمومی به منظور از بین بردن پاتوژن های انسانی و از بین بردن یا کاهش فعالیت میکروارگانیسم های فاسد کننده معرفی شد. اندازهگیری بار میکروبی شیر یکی از آزمونهایی است که در مجموعه آزمایشگاههای همکار نیکوفارمد آریا انجام میشود.
زنده ماندن باکتریها در شیر پس از عملیات حرارتی را میتوان با استفاده از سه شاخص زنده ماندن مختلف ارزیابی کرد: (1) کشت در محیط پلیت آگار و شمارش واحد تشکیل دهنده کلنی (CFU)، (2) ارزیابی کمی مولکولی با کمک اندازهگیری میزان بیان ژن گزارشگر gfpو (3) بررسی متابولیسم باکتریایی به روش رد پروپیدیوم یدید و آزمایشهای احیای متیلن بلو و فسفاتاز. این روشها به طور معمول میتواند برای اندازهگیری بار میکروبی در شیر پاستوریزه استفاده شوند. اندازهگیری بار میکروبی شیر یکی از آزمونهایی است که در مجموعه آزمایشگاههای همکار نیکوفارمد آریا انجام میشود.
شمارش کلی میکروارگانیسمها در محیط کشت پلیت برای تعیین بار میکروبی موجود در مقدار مشخصی شیر، معمولاً یک میلی لیتر (میلی لیتر) استفاده می شود. در نهایت میزان بار میکروبی فراروده به صورت CFU/ml گزارش میشود. بدین ترتیب از اندازهگیری بار میکروبی شیر برای درجهبندی کیفی شیر استفاده میشود. اندازهگیری بار میکروبی شیر یکی از آزمونهایی است که در مجموعه آزمایشگاههای همکار نیکوفارمد آریا انجام میشود.





